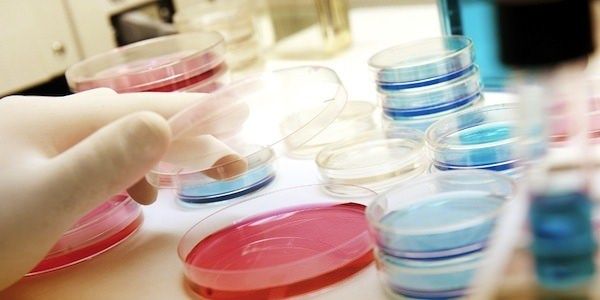
Prese la leucemia per colpa del lavoro, risarcito

Prese la leucemia per colpa del lavoro, risarcito
COSENZA Ha contratto la leucemia a causa del suo lavoro. La Corte di appello di Catanzaro ha riconosciuto la patologia del signore O. S., tecnico di laboratorio di una struttura sanitaria pubblica de…
COSENZA Ha contratto la leucemia a causa del suo lavoro. La Corte di appello di Catanzaro ha riconosciuto la patologia del signore O. S., tecnico di laboratorio di una struttura sanitaria pubblica del Cosentino, come malattia professionale. La complessa vicenda personale e processuale ha inizio nel 1995 quando gli viene diagnosticata la leucemia mieloide cronica e inizia il suo calvario esistenziale che si protrae ancora oggi. Nel 2008 – poiché all’esito della domanda di invalidità civile non gli veniva riconosciuta la percentuale del 100% – l’uomo si rivolge agli avvocati Carmelinda De Marco e Giovanni Carlo Tenuta, affinché agissero giudizialmente contro l’Inps per ottenere i benefici previsti dalla legge 104/1992. L’avvocato Tenuta, invece, dopo avere interrogato il cliente sulle mansioni svolte e sulle sostanze manipolate, richiese a un medico di fiducia di verificare se la leucemia potesse derivare dal lavoro svolto e di determinare, all’esito, il danno biologico. Ottenuto il certificato medico, i due legali, poiché avevano inutilmente richiesto all’Inail di riconoscere, in via amministrativa, la patogenesi lavorativa e di liquidare la relativa rendita, all’inizio del 2010 hanno deciso di agire processualmente.
IL RICORSO DEI LEGALI Nel ricorso proposto al giudice del lavoro del Tribunale di Cosenza i legali sostenevano che il fattore scatenante della leucemia fosse da rinvenire nella esposizione del lavoratore a sostanze nocive e cancerogene, quali il benzene e la formaldeide che, tra l’altro, venivano manipolate e inspirate dal tecnico di laboratorio. Ma il consulente, nominato dal giudice, redigeva una perizia nella quale affermava che la leucemia mieloide era determinata dal fumo di sigaretta. Una perizia prontamente contestata dai difensori del lavoratore che costringevano il consulente a comparire per ben due volte in udienza per rendere chiarimenti al giudice e, alla fine, sulle domande dell’avvocato Giovanni Carlo Tenuta, riconosceva che il fumo di sigaretta sprigiona diossina e formaldeide e che queste due sostanze, al pari di quelle che, durante la preparazione dei reperti isologici, venivano inalate o erano aerodisperse, avevano determinato l’insorgenza della malattia. Il consulente precisava, inoltre, che non era in grado, né lui né nessuno altro, di potere stabilire se fosse prevalente il tabagismo o la esposizione lavorativa a quelle sostanze. Pur essendo emerso in termini giuridici che i due fattori di rischio (fumo ed esposizione alle sostanze nocive) si equivalessero, il Tribunale di Cosenza Sezione Lavoro, rigettava la domanda dell’ammalato.
TUTTO COLPA DI UNA SIGARETTA L’avvocato Tenuta non accettava che il giudice avesse liquidato la questione dando rilevanza al fumo di sigaretta e, pertanto, proponeva, assieme all’avvocato Carmelinda De Marco, un articolato appello nel quale, tra l’altro, evidenziava che il Tribunale di Cosenza aveva omesso di considerare se il tabagismo avesse interrotto il nesso causale derivante dagli altri fattori di rischio (le due sostanze aerodisperse), – di effettuare un valido giudizio controfattuale in base al quale potesse escludere l’incidenza di fattori di rischio alternativi, di accertare se sussistesse una qualsiasi relazione sinergica tra tabagismo ed esposizione al benzene e alla formaldeide, che provocasse un acceleramento della insorgenza della malattia.
Di contro, l’Inail eccepiva, non solo che il diritto del lavoratore era prescritto in quanto la malattia era stata diagnosticata nel lontano 1995 e la denuncia fatta direttamente dal lavoratore tramite i suoi legali era avvenuta a distanza di 15 anni, ma anche che non sussistevano altre sentenze che avessero riconosciuto l’origine professionale della leucemia mieloide, ovvero precedenti giurisprudenziali che affermassero che tale malattia fosse provocata dal benzene e dalla formaldeide.
LA SVOLTA IN APPELLO Ma, nei giorni scorsi, la Corte di Appello di Catanzaro presieduta dai giudici Emilio Sirianni, Barbare Fatale e Rosario Murgiada, senza disporre ulteriori accertamenti o supplementi di istruttoria, ha riconosciuto il diritto del lavoratore a percepire la rendita per malattia professionale commisurata a un danno biologico del 30 per cento, e condannava l’Inail a pagare sia gli arretrati maturati dal 2009 che le spese legali.
Mirella Molinaro
m.molinaro@corrierecal.it